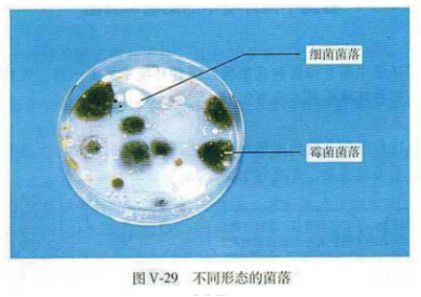

[综合题]《细菌和真菌》细菌很小,大部分的真菌个体也比较小。为了便于观察和检测,可以在培养皿中加入适于细菌或真菌生长的物质。制成培养基来培养,在培养基上,它们会迅速繁殖,形成肉眼可见的菌落(一个细菌或真菌繁殖后形成的肉眼可见的集合体,称为菌落)。
上图就是在培养皿上生长的菌落,请观察它们的形态。
细菌的菌落比较小,表面或光滑黏稠,或粗糙干燥。真菌的菌落一般比细菌菌落大几倍到几十倍。霉菌形成的菌落常呈绒毛状、絮状或蜘蛛网状,有时还能呈现红、褐、绿、黑、黄等不同的颜色。从菌落的形态、大小和颜色,可以大致区分细菌和真菌,以及它们的不同种类。